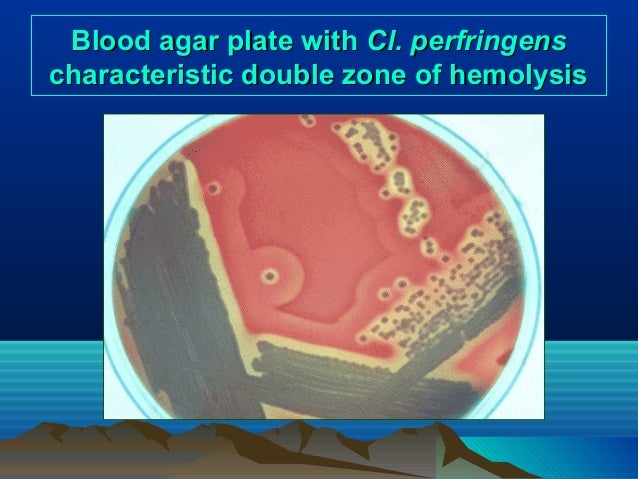

Is Bacillus cereus alpha or beta-hemolytic?
beta-hemolyticBacillus cereus is a Gram-positive, rod-shaped, facultatively anaerobic, motile, beta-hemolytic, spore-forming bacterium commonly found in soil, food and marine sponges.
What type of hemolysis is Bacillus cereus?
beta-hemolysisColonies are surroundend by a wide zone of beta-hemolysis. Bacillus cereus is an endemic, soil-dwelling, Gram-positive, rod-shaped, beta hemolytic bacterium.
Is Bacillus beta-hemolytic?
Bacillus species are easily recovered on blood and chocolate agars and grow optimally at environmental temperatures (25 to 37°C). All species except B. anthracis are motile and beta-hemolytic on blood agar.
Is Bacillus cereus gamma hemolytic?
B. anthracis is non-hemolytic on sheep blood agar, susceptible to penicillin, lysed by the gamma phage, and non-motile. Conversely, B. cereus is hemolytic on sheep blood agar, resistant to penicillin, resistant to lysis by the gamma phage, and motile.
What bacteria are beta-hemolytic?
Introduction. Pyogenic β-hemolytic streptococci (including Group A, C and G Streptococcus) are some of the most important Gram-positive bacterial pathogens in human medicine. Although effective therapy is available, invasive streptococcal infections are associated with a significant disease burden.
What bacteria is beta hemolysis?
Streptococcus pyogenes, or Group A beta-hemolytic Strep (GAS), displays beta hemolysis. Some weakly beta-hemolytic species cause intense beta hemolysis when grown together with a strain of Staphylococcus. This is called the CAMP test. Streptococcus agalactiae displays this property.
Is Streptococcus beta or alpha hemolytic?
The most significant streptococcal pathogen is S. pyogenes, which is beta-hemolytic and in Lancefield group A and is thus denoted as group A beta-hemolytic streptococci (GABHS). ) sometimes occur ≥ 2 weeks after infection.
What is beta-hemolytic vs Alpha hemolytic?
Beta-hemolysin breaks down the red blood cells and hemoglobin completely. This leaves a clear zone around the bacterial growth. Such results are referred to as β-hemolysis (beta hemolysis). Alpha-hemolysin partially breaks down the red blood cells and leaves a greenish color behind.
Is Bacillus subtilis beta-hemolytic?
Typical Bacillus spp. exhibit large, flat colonies on non-selective media. They are often beta-hemolytic.
Does Bacillus cereus cause haemolysis?
Conclusions: Bacillus cereus infection can have a fulminant clinical course that may be complicated by massive intravascular hemolysis.
Is E coli beta or gamma hemolytic?
beta-hemolyticE coli is a gram-negative bacillus that grows well on commonly used media. It is lactose-fermenting and beta-hemolytic on blood agar. Most E coli strains are nonpigmented.
What is the difference between beta and gamma hemolysis?
In beta hemolysis, the complete destruction of red blood cells occurs. Hence, clear zones are produced around the bacterial colonies in the blood agar plates. In gamma hemolysis, red blood cells are not destroyed due to the absence of hemolysin enzymes. Hence, no clearing will take place in gamma hemolysis.
Does Bacillus cereus cause haemolysis?
Conclusions: Bacillus cereus infection can have a fulminant clinical course that may be complicated by massive intravascular hemolysis.
What type of hemolysis is Bacillus subtilis?
Bacillus subtilis is a facultative anaerobic Gram-positive non-pathogenic bacterium that includes members displaying hemolytic activity.
What type of hemolysis is enterococcus?
Enterococci are catalase-negative gram-positive cocci that can appear singly or in pairs or short chains. They are facultative anaerobes that grow optimally at 35° to 37° C and are usually α-hemolytic or nonhemolytic on sheep blood agar.
What type of hemolysis is seen with most staphylococcal colonies?
What type of hemolysis is seen with most staphylococcal colonies? Gamma hemolysis is the predominant type.
What are the toxins in Bacillus cereus?
Among these secreted toxins are four hemolysins, three distinct phospholipases, an emesis-inducing toxin, and proteases.[1][2] Bacillus cereus is a toxin-producing facultatively anaerobic gram-positive ...
Where is Bacillus cereus found?
The bacteria is commonly found in the environment, is often found in soil and vegetation, and can be present in foods.
What is a CME/CE?
Earn continuing education credits (CME/CE) on this topic. Introduction. Bacillus cereusis a toxin-producing facultatively anaerobic gram-positive bacteria. The bacteria is commonly found in the environment, is often found in soil and vegetation, and can be present in foods. It can quickly multiply at room temperature.
What is diarrhea related to?
Specifically, the diarrheal illness is often related to meats, milk, vegetables, and fish. The emetic-type illness is most often associated with rice products, but it has also been associated with other types of starchy products such as potato, pasta, and cheese products.
Which type of cell produces enterotoxins?
In the gastrointestinal tract (small intestine), vegetative cells, ingested as viable cells or spores, produce and secrete a protein enterotoxin and induce a diarrheal syndrome, whereas emetic toxin, a plasmid-encoded cyclic peptide (cereulide), is produced in food products and ingested as a formed toxin.
Is Bacillus cereus anaerobic?
Bacillus cereus is a facultatively anaerobic, toxin-producing gram-positive bacteria that can be found in soil vegetation and even food. This may cause two types of intestinal illness, one diarrheal, and one causing nausea and vomiting. This activity outlines the evaluation and treatment of Bacillus cereus and reviews the role ...
How long does it take for B. cereusinfection to heal?
Treatment for most patients is symptomatic care with oral hydration. Most patients recover within 24 hours after symptom onset. Empiric antibiotic therapy for gastrointestinal syndromes secondary to B. cereusinfections is not indicated. In severe cases, intravenous fluid hydration may be necessary. [9][10][11]
Which cells do Bacillus cereus spores adhere to?
Bacillus cereusspores, which are hydrophobic and have projecting appendages, adhere to Caco-2 and small-intestine epithelial cells (5) and HeLa cells (110). In these studies, spores adhered in aggregates, which, when germinating, released high concentrations of tissue-destructive toxins.
How does B. cereus colonize the oral cavity?
cereuseither through the inhalation of spores or by vegetative bacteria passing through in B. cereus-contaminated food (31, 44). Foci can be established by the entrapment of bacteria in furrows in the oral cavity in which the bacterium may develop locally and elaborate toxins, which can spread to adjacent tissues, or the bacterium can disseminate to other body sites. A report by Strauss et al. (124) of the development of pseudomembranous tracheobronchitis in a 52-year-old female patient with aplastic anemia suggests that treatment-mediated damage to the buccal mucosa may expedite spore/vegetative cell adherence and colonization. Fiber-optic bronchoscopy of the patient revealed a severely inflamed tracheal and bronchial mucosa accompanied by white diphtheria-like membranes obstructing the lower lobe bronchi on the left side. Over an 8-h period, the membranes spread and obstructed the entire visible bronchial system. B. cereuswas recovered from blood and bronchoalveolar lavage cultures and the membrane biopsy specimen. As this patient's initial symptoms included chest pain, yellowish sputum, and a rapid progression of the infection, the authors likened her infection to pulmonary anthrax. B. cereuscolonization of the oral cavity, as noted here and elsewhere (31, 44), may well be an underappreciated first stage in the pathogenesis of pulmonary as well as systemic infections in immunocompromised individuals.
What are the toxins in B. cereus?
Among these secreted toxins are four hemolysins (56), three distinct phospholipases, an emesis-inducing toxin, and three pore-forming enterotoxins: hemolysin BL (HBL), nonhemolytic enterotoxin (NHE), and cytotoxin K (91, 92, 114). In the gastrointestinal tract (small intestine), vegetative cells, ingested as viable cells or spores, produce and secrete a protein enterotoxin and induce a diarrheal syndrome, whereas emetic toxin, a plasmid-encoded cyclic peptide (cereulide), is produced in food products and ingested preformed. In rabbit ligated ileal-loop assays, culture filtrates of enterotoxigenic strains induce fluid accumulation and hemolytic, cytotoxic, dermonecrotic, and vascular permeability activities in rabbit skin (13).
What is the morphology of B. cereus?
anthracisdisplay a range of morphological forms depending upon the milieu in which they are observed. In Gram-stained smears of body fluids such as anterior-chamber aspirates or broth cultures, B. cereuspresents as straight or slightly curved slender bacilli with square ends singly or in short chains (Fig. (Fig.1).1). Clear-cut junctions separating members of the chain are distinctly displayed. Gram-stained smears prepared from agar growth will show more uniform bacillary morphology with oval, centrally situated spores, which do not distort the bacillary form. In tissue sections such as those shown in Fig. Fig.2,2, long, slender, bacillary forms may predominate, with some clearly displaying polyhydroxybutyrate vacuoles, which may be confused with spores. Long filamentous forms characterized as filamentation may also show beading, which may preclude identification as a Bacillusspecies (Fig. (Fig.3).3). In wet preparations of body fluids or broth cultures, the peritrichous bacilli are motile, displaying a leisurely gait rather than darting motility.
How does biofilm formation occur?
Biofilm formation can result from cell-to-cell and cell-surface contact, which leads to the formation of microcolonies. The release of planktonic bacteria from the biofilm can result in the formation of additional biofilms, thereby maintaining persistence (33).
What is the most common aerobic spore bearer in soil?
B. cereusmay be the most common aerobic spore bearer in many types of soil and in sediments, dust, and plants (107). B. cereusis also frequently present in food production environments due to the adhesive nature of its endospores (7). This characteristic enables the bacterium to spread to all kinds of food.
What is the reservoir of B. cereus?
The natural environmental reservoir for B. cereusconsists of decaying organic matter, fresh and marine waters, vegetables and fomites, and the intestinal tract of invertebrates (71), from which soil and food products may become contaminated, leading to the transient colonization of the human intestine (53). Spores germinate when they come into contact with organic matter or within an insect or animal host (7). A multicellular filamentous growth pattern containing refractile inclusions, termed arthromitus (rooted), has been observed in the guts of certain arthropods, which is regarded as the normal intestinal stage in soil-dwelling insects (95). In this setting, as long rod-shaped bacteria, the bacilli lose their flagella, attach to the arthropod intestinal epithelium, and sporulate (95). B. cereusalso has a saprophytic life cycle in which spores germinate in soil, with the production of a vegetative bacillus, which could then sporulate, maintaining the life cycle (7). Defecation by or death of the host releases cells and spores into the soil, where vegetative cells may sporulate and survive until their uptake by another host (71, 135). Furthermore, when B. cereusgrows in soil, it undergoes a switching from a single-cell to a multicellular phenotype, which allows it to translocate through the soil (135). This morphogenic phase is analogous to B. cereusswarming on agar media (118).
What is the bacteria that is contracted from rice?
The bacteria is classically contracted from fried rice dishes that have been sitting at room temperature for hours. B. cereus bacteria are facultative anaerobes, and like other members of the genus Bacillus, can produce protective endospores. Its virulence factor s include cereolysin and phospholipase C. The Bacillus cereus group comprises seven ...
What is the micrograph of Bacillus cereus?
Electron micrograph of Bacillus cereus. Bacillus cereus is a Gram-positive, rod-shaped, facultatively anaerobic, motile, beta-hemolytic, spore forming bacterium commonly found in soil and food. The specific name, cereus, meaning "waxy" in Latin, refers to the appearance of colonies grown on blood agar.
How many B. cereus organisms are there in food?
In case of foodborne illness, the diagnosis of B. cereus can be confirmed by the isolation of more than 100,000 B. cereus organisms per gram from epidemiologically-implicated food, but such testing is often not done because the illness is relatively harmless and usually self-limiting.
How long does it take for B. cereus to double?
At 30 °C (86 °F), a population of B. cereus can double in as little as 20 minutes or as long as 3 hours, de pending on the food product. Food. Minutes to double, 30 °C (86 °F) Hours to multiply by 1,000,000. Milk.
What is the pathogen of B. cereus?
Pathogenesis. B. cereus is responsible for a minority of foodborne illnesses (2–5%), causing severe nausea, vomiting, and diarrhea. Bacillus foodborne illnesses occur due to survival of the bacterial endospores when infected food is not, or inadequately, cooked.
What is the cause of emetic syndrome?
The timing of the toxin production was previously thought to be possibly responsible for the two different courses of disease, but in fact the emetic syndrome is caused by a toxin, cereulide, found only in emetic strains and is not part of the "standard toolbox" of B. cereus.
What is the ISO 7931 method for enumeration of B. cereus?
Because of B. cereus ' ability to produce lecithinase and its inability to ferment mannitol, there are some proper selective media for its isolation and identification such as mannitol-egg yolk-polymyxin (MYP) and polymyxin-pyruvate-egg yolk-mannitol-bromothymol blue agar (PEMBA). B. cereus colonies on MYP have a violet-red background and are surrounded by a zone of egg-yolk precipitate.
What is the most common species of Bacillus cereus?
B. cereus is the most commonly encountered species of Bacillus in opportunistic infections including posttraumatic eye infections, endocarditis, and bacteremia. The pathogenesis of B. cereus ocular infections is also incompletely defined.
What color are Bacillus cereus colonies?
Bacillus cereus colonies turn pink-orange with an opaque halo. The chromogenic agar has been suggested for the enumeration of the B. cereus group as a substitute for MYP. Typical colonies will grow as pink-orange uniform colonies surrounded by a zone of precipitation.
What temperature does Bacillus cereus grow?
Most Bacillus spp grow readily on nutrient agar or peptone media. The optimum temperature for growth varies from 20°C to 40°C, mostly 37°C. B. cereus is mesophilic and is capable of adapting to a wide range of environmental conditions.
What is the habitat of Bacillus cereus?
Habitat of Bacillus cereus. Bacillus cereus is isolated from soil, vegetables, milk, cereals, spices, fried rice, cooked poultry and meats, soups, and desserts. It is also found in mashed potatoes, beef stew, apples, hot chocolates sold in vending machines, and other improper food handling areas.
What media is used for plating B. cereus?
The MYP agar has been the standard media for plating B. cereus, but it has little selectivity so background flora is not inhibited and can mask the presence of B. cereus. B. cereus colonies are usually lecithinase-positive and mannitol-negative on MYP agar.
What is the color of B. cereus?
On 5% sheep blood agar at 37°C, B. cereus colonies are large, feathery, dull, gray, granular, spreading colonies, and opaque with a rough matted surface and irregular perimeters.
Why are colony perimeters irregular?
Colony perimeters are irregular and represent the configuration of swarming from the site of initial inoculation, perhaps due to B. cereus swarming motility.
What is the name of the bacteria that survives in rice?
Ankolekar C, Labbé RG. Survival during cooking and growth from spores of diarrheal and emetic types of Bacillus cereus in rice. J Food Prot 2009; 72:2386.
What are the different types of Bacillus cereus?
The Bacillus cereus group is comprised of eight closely related species: B. cereus, B. cytotoxicus, B. mycoides, B. pseudomycoides, B. thuringiensis, B. weihenstephanensis, B. toyonensis, and B. anthracis [ 1-7 ]. Most human non-anthracis Bacillus spp infections are caused by B. cereus, although infections with other species within the B. cereus group have also been described [ 1,2 ]. Not all isolates are associated with invasive disease. B. cereus is associated with nosocomial and opportunistic infections, particularly in immunocompromised patients, intravenous drug users, and patients with indwelling or implanted devices. B cereus is also associated with syndromes such as food poisoning due to toxin production.
What is the name of the disease that masquerades as anthrax?
Cone LA, Dreisbach L, Potts BE, et al. Fatal Bacillus cereus endocarditis masquerading as an anthrax-like infection in a patient with acute lymphoblastic leukemia : case report. J Heart Valve Dis 2005; 14:37.
What is the CDC?
Centers for Disease Control and Prevention (CDC). Notes from the field: Contamination of alcohol prep pads with Bacillus cereus group and Bacillus species--Colorado, 2010. MMWR Morb Mortal Wkly Rep 2011; 60:347.
What is Pearson's HE?
Pearson HE. Human infections caused by organisms of the bacillus species. Am J Clin Pathol 1970; 53:506.
What is Torjesen I?
Torjesen I. Parenteral nutrition product is suspected as cause of 18 cases of septicaemia in neonates. BMJ 2014; 348:g3763.
Can Bacillus cereus be recovered from blood?
Bacillus species are easily recovered on blood and chocolate agars and grow optimally at environmental temperatures (25 to 37°C). All species except B. anthracis are motile and beta-hemolytic on blood agar. Colonies have an irregular perimeter and appear dull gray and opaque on sheep blood agar. On egg yolk agar, members of the B. cereus group produce a zone of opacification due to lecithinase production.
What is the ASM Sentinel Level Clinical Laboratory Guideline for B. anthracis?
anthracis to rule out or refer isolates of Bacillus spp. that produce non-hemolytic colonies with a ground glass appearance and are non-motile. Until new guidelines are available, the following recommendations should be considered:
What is B. cereus biovar anthracis?
B. cereus biovar anthracis was first described as an agent of anthrax-like disease in gorillas and chimpanzees in Cameroon and Côte d’Ivoire . The organism has since been recovered from an elephant and goats in other countries of Africa. The CDC has determined that B. cereus biovar anthracis has all of the virulence determinants and the biothreat potential of B. anthracis. No human infections caused by B. cereus biovar anthracis have been described at this time. B. cereus biovar anthracis isolates are non-hemolytic, like B. anthracis, and motile, like B. cereus. The characteristics of B. cereus biovar anthracis compared to B. anthracis and B. cereus are summarized in the following table:
How to determine if an isolate is significant?
Suspect isolates should be investigated to determine if the isolate is significant regardless of motility. If the isolate was recovered from a sterile site or from a wound culture, follow the local public health guidelines to assess whether the public health lab or clinical lab should contact the patient’s attending physician to determine the likely clinical significance (e.g., does the patient have an anthrax-like clinical syndrome?). Appropriate travel history should be obtained as well. If the isolate is deemed significant, the local LRN reference laboratory should be contacted to obtain guidance regarding the need to refer the isolate for confirmatory testing.
Is Bacillus spp. a hemolytic?
Isolates can appear weakly hemolytic upon extended incubation (48h) in ambient atmosphere and are more hemolytic in 5% CO 2 at 48h. Semi-solid medium is recommended for motility to ensure consistent results.
What host factors protect against this infection?
There is no known specific host defect that predisposes to this rare infection. In the limited setting of persistent Bacillus spp. bacteremia, biofilm on a vas cular catheter is a likely scenario and removal of the catheter is very helpful in resolving the infection.
What common complications are associated with infection with this pathogen?
Food poisoning is a self-limited short duration disease, normally involving some combination of nausea, vomiting and diarrhea. Pyogenic infections can follow eye injury or surgery, and have local manifestations in the globe. Disease elsewhere in the body affects the involved organ in much the same way that other bacterial infections do.
How should I identify the organism?
This bacterium can live vegetatively in many environmental niches and forms spores readily.
How does this organism cause disease?
Unlike B. anthracis that contains significant toxins that account for its pathogenic potential, most invasive infections caused by Bacillus spp. are felt to be largely related to the presence of the organism and the tissue response. There is no person-to-person transmission. Tissue destruction seems to be greatest when there is foreign material or non-viable tissue for the organism to persist in.
How to treat pyogenic infection?
Treatment of pyogenic infection is usually accomplished by removal of foreign material (if present and possible to remove) and addition of antibiotics. There are no structured studies comparing various regimens so the choice of drug is based either on susceptibility test of actual isolates or general empiric rules if there is no opportunity to perform in vitro susceptibility testing. Antibiotic susceptibility is variable and sometimes predicted by species. B. cereus tends to be resistant to most beta-lactams except carbapenems. Vancomycin is usually active and fluoroquinolones are also recommended. Clindamycin has good in vitro and in vivo activity, although some strains are resistant.
What is the best treatment for Bacillus spp.?
If treatment is indicated, the agents most likely to work include fluoroquinolones and carbapenems. It may also be important to remove foreign bodies and/or to drain pus because Bacillus spp. can thrive within biofilm and may be difficult to eradicate without removal of the spores and vegetatively dormant members of the biofilm community.
What is the mechanism of resistance in B. cereus?
In the vegetative form, there are several mechanisms of resistance. B. cereus produces a beta-lactamase that confers resistance to most penicillins and cephalosporins but retains susceptibility to carbapenems. There are plasmid-based mechanisms of resistance for tetracyclines.
Overview
Bacillus cereus is a Gram-positive, rod-shaped, facultatively anaerobic, motile, beta-hemolytic, spore-forming bacterium commonly found in soil, food and marine sponges. The specific name, cereus, meaning "waxy" in Latin, refers to the appearance of colonies grown on blood agar. Some strains are harmful to humans and cause foodborne illness, while other strains can be beneficial as pr…
History
Colonies of B. cereus were originally isolated from an agar plate left exposed to the air in a cow shed. In the 2010s, examination of warning letters issued by the US Food and Drug Administration issued to pharmaceutical manufacturing facilities addressing facility microbial contamination revealed that the most common contaminant was B. cereus.
Several new enzymes have been discovered in B. cereus, such as AlkC and AlkD, both of which a…
Ecology
Like most Bacilli, the most common ecosystem of Bacillus cereus is the soil. In concert with Arbuscular mycorrhiza (and Rhizobium leguminosarum in clover), they can up-regulate plant growth in heavy metal soils by decreasing heavy metal concentrations via bioaccumulation and biotransformation in addition to increasing phosphorus, nitrogen, and potassium uptake in certain plants. B. cereus was also shown to aid in survival of earthworms in heavy metal soils resulting f…
In agriculture
B. cereus B25 is a biofungicide. Figueroa-López et al. 2016 reduce Fusarium verticillioides growth using this strain. B25 shows promise for reduction of mycotoxin concentrations in grains.
Pathogenesis
B. cereus is responsible for a minority of foodborne illnesses (2–5%), causing severe nausea, vomiting, and diarrhea. Bacillus foodborne illnesses occur due to survival of the bacterial endospores when infected food is not, or is inadequately, cooked. Cooking temperatures less than or equal to 100 °C (212 °F) allow some B. cereus spores to survive. This problem is compounded when food is then improperly refrigerated, allowing the endospores to germinate. Cooked foods …
Spore elimination
While B. cereus vegetative cells are killed during normal cooking, spores are more resistant. Viable spores in food can become vegetative cells in the intestines and produce a range of diarrheal enterotoxins, so elimination of spores is desirable. In wet heat (poaching, simmering, boiling, braising, stewing, pot roasting, steaming), spores require more than 5 minutes at 121 °C (250 °F) at the coldest spot to be destroyed. In dry heat (grilling, broiling, baking, roasting, searin…
Diagnosis
In case of foodborne illness, the diagnosis of B. cereus can be confirmed by the isolation of more than 100,000 B. cereus organisms per gram from epidemiologically-implicated food, but such testing is often not done because the illness is relatively harmless and usually self-limiting.
For the isolation and enumeration of B. cereus, there are two standardized methods by International Organization for Standardization (ISO): ISO 7932 and ISO 21871. Because of B. cere…
Prognosis
Most emetic patients recover within 6 to 24 hours, but in some cases, the toxin can be fatal via fulminant hepatic failure. In 2014, 23 newborns in the UK receiving total parenteral nutrition contaminated with B. cereus developed septicaemia, with three of the infants later dying as a result of infection.